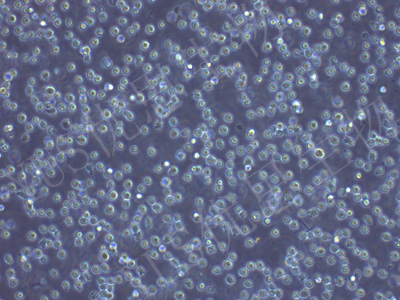

产品中心
产品中心
-

Hep G2 人肝母细胞瘤细胞(STR鉴定)
货号:YLH370规格: 1*10^6 -
Karpas-299 人间变性大细胞淋巴瘤细胞(STR鉴定)
货号:YLH371规格: 1*10^6 -

NCCIT 人畸胎癌细胞(STR鉴定)
货号:YLH372规格: 1*10^6 -

U-118 MG 人脑星形胶质母细胞瘤(STR鉴定)
货号:YLH373规格: 1*10^6 -

MHCC-97L 人低转移性肝癌细胞(STR鉴定)
货号:YLH374规格: 1*10^6 -

HEC-1-A 人子宫内膜腺癌细胞(STR鉴定)
货号:YLH375规格: 1*10^6 -

U266 人骨髓瘤细胞(STR鉴定)
货号:YLH376规格: 1*10^6 -

NCI-H1299 人非小细胞肺癌细胞(STR鉴定)
货号:YLH377规格: 1*10^6 -

SUP-B15 人Ph+急淋白血病细胞(STR鉴定)
货号:YLH378规格: 1*10^6 -

PC-3M 人前列腺癌细胞(STR鉴定)
货号:YLH379规格: 1*10^6 -

MM.1S 人多发性骨髓瘤细胞(STR鉴定)
货号:YLH380规格: 1*10^6 -

LS180 人结肠癌细胞(STR鉴定)
货号:YLH381规格: 1*10^6
在线咨询
Online consultation

关注微信公众号


